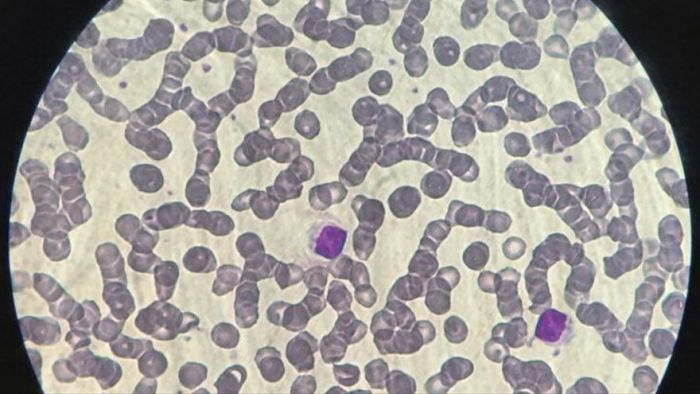

Physical Address
304 North Cardinal St.
Dorchester Center, MA 02124
Physical Address
304 North Cardinal St.
Dorchester Center, MA 02124

Los resultados preliminares de estudios de inmunidad celular T muestran que se produce una potente respuesta en personas vacunadas, tanto con el esquema completo de la vacuna como con una sola dosis.

Buenos Aires, 14 de julio de 2021 – Surgida en el marco de la Unidad Coronavirus (del Ministerio de Ciencia, Tecnología e Innovación, la Agencia I+D+i y el CONICET), el pasado abril un equipo de científicas y científicos del Instituto de Biología y Medicina Experimental (IBYME – CONICET) liderado por el reconocido investigador Gabriel Rabinovich, lanzó la Plataforma COVID-T con el objetivo de monitorear la respuesta linfocitaria T antígeno-específica en pacientes recuperados de COVID-19 y en personas vacunadas.
MÁS NOTICIAS LEÉ TAMBIÉN:
Tasas de plazos fijos: ¿cuánto pagan hoy miércoles 29 de abril? los principales BancosLos estudios estuvieron coordinados por Montana Manselle Cocco y Florencia Veigas y participaron del equipo de Rabinovich Ada Blidner, Nicolás Torres, Tomás Dalotto, Alejandro Cagnoni, Pablo Hockl, Camila Bach, Marco Scheidegger, Yamil Mahmoud, Valeria Wiersba y Alicia Sirino.
“La Plataforma permite estudiar la respuesta inmunológica T, un tipo de inmunidad distinta a la que estudiamos cuando evaluamos presencia de anticuerpos, y su duración en el tiempo frente al virus SARS-CoV-2 en personas que recibieron una y dos dosis de las vacunas aplicadas en la Argentina, en este caso en la Provincia de Buenos Aires, y en pacientes recuperados de la enfermedad”, explicó Gabriel Rabinovich.
“El Dr. Rabinovich y su equipo del CONICET en el IBYME desarrollaron esta plataforma que permite evaluar en forma integral la respuesta inmune que generan las vacunas que se emplean en el país. Los resultados preliminares validan no sólo la robustez del desarrollo científico, único en la región, sino también la excelente respuesta de las vacunas que se están utilizando. Felicito a los integrantes del equipo de Rabinovich, que contribuyen con su conocimiento y dedicación a enfrentar la pandemia”, sostuvo el ministro de Ciencia, Tecnología e Innovación de la Nación, Roberto Salvarezza.
Por su parte, el ministro de Salud provincial, Daniel Gollan adelantó ayer durante la conferencia de prensa en Gobernación, que el resultado sobre el primer análisis del efecto de la enfermedad y las vacunas es extraordinario: “Hemos notado una excelente respuesta en la activación de toda la línea de los linfocitos T ante las vacunas probadas: Sinopharm y Sputnik-V”, dijo el ministro, a la vez que indicó que próximamente se publicará dicho análisis.
Linfocitos T: la patrulla protectora
“Hay dos tipos de respuestas inmunológicas frente al virus SARS-CoV-2, una de ellas mediada por anticuerpos, producidos por células plasmáticas provenientes de linfocitos B y otra, por linfocitos T (citotóxicos CD8) que destruyen las células infectadas (como las pulmonares). Por otro lado, los linfocitos T colaboradores (CD4) cooperan tanto con la respuesta de anticuerpos como con la respuesta T citotóxica. De allí la importancia de la respuesta inmunológica T para evaluar la respuesta inmunológica completa. Hasta el momento lo que se mide en los test serológicos son los anticuerpos, y se hace a partir de ensayos de ELISA que se utilizan en kits”, detalló el investigador. “Pero de este modo nos perdemos una parte central de la respuesta inmune, los linfocitos T -advierte-. Es por esto que es importante medirlos para conocer la respuesta integral a las vacunas”.
La duración en el tiempo de la inmunidad depende de lo que llamamos la ‘memoria celular’: “los linfocitos de memoria son aquellas células del sistema inmune que se encuentran en la sangre, que han estado en contacto previamente con el virus o una parte de él, ya sea porque la persona se ha vacunado o porque se ha infectado con SARS-CoV-2. Estas células re-circulan por el organismo, por la sangre y los tejidos (como una patrulla protectora) a la espera del reingreso de ese mismo virus para poder reaccionar. Los linfocitos de memoria, como indica la palabra, tienen una memoria inmunológica y recuerdan a aquel antígeno que vieron anteriormente para reaccionar nuevamente con mayor potencia y rapidez”, describió Rabinovich.
Sobre el proceso de estudio
Para el estudio actual se procesaron muestras de personas inoculadas con las distintas vacunas disponibles en la Provincia de Buenos Aires. “La puesta a punto de la plataforma no fue tarea simple porque los linfocitos T de memoria contra SARS-CoV-2 en individuos infectados, recuperados o vacunados demandan una técnica compleja para detectarse, deben ser activados in vitro con los péptidos específicos del virus y no todos los péptidos los activan por igual, lo cual consume un tiempo importante de optimización”, explicó Rabinovich.
Para hacer el ensayo, los especialistas deben obtener sangre de la persona vacunada y, una vez en el laboratorio, purifican las células mononucleares que contienen los linfocitos T, (entre otros tipos de células). Estas células son estimuladas con fragmentos específicos del virus SARS-CoV-2.
Una vez cumplidos los plazos de cultivo, los investigadores determinan la activación de los linfocitos T a través del monitoreo de una serie de moléculas presentes en la superficie y en el interior de las células por citometría de flujo: “Actualmente trabajamos con esta plataforma en nuestro laboratorio, y nos permitirá realizar un estudio epidemiológico de la memoria T a lo largo del tiempo en individuos que recibieron distintas vacunas, con una y dos dosis”, especificó el investigador.
Colaboración e interdisciplinariedad
Gracias a la plataforma “COVID-T” se pudo comenzar a estudiar la magnitud y naturaleza de linfocitos T de memoria generados en voluntarios inmunizados con diferentes esquemas de vacunación en la Provincia de Buenos Aires. La misma proveerá información útil para la toma de decisiones a corto, mediano y largo plazo, y para el diseño de nuevas estrategias de vacunación en el escenario de la pandemia por SARS-CoV-2.
Esta plataforma viene a dar cuenta del trabajo articulado entre equipos de trabajo científico comprometidos, el Estado en sus distintos niveles y la apuesta a la construcción del conocimiento científico para resolver problemas urgentes.
La adaptación de los objetivos de trabajo de nuestros/as científicos/as y su compromiso, el aporte desde lo presupuestario y un Estado que toma decisiones basadas en la construcción de conocimiento de calidad local ha permitido enormes avances en materia de ciencia y de salud, que han permitido tomar decisiones adecuadas para mitigar esta pandemia y cuidar a nuestra población.
“El trabajo realizado por el equipo que lidera Gabriel es resultado de la acción coordinada entre el Ministerio, la Agencia y la Provincia de Buenos Aires con nuestras/os investigadoras/es”, expresó la presidenta del CONICET, Ana Franchi. “La plataforma COVID-T -única en la región- vuelve a reafirmar el compromiso del Estado en construir y cimentar el conocimiento científico nacional. Ha sido una tarea compleja, que puso de manifiesto el espíritu solidario y la capacidad de nuestras/os científicas/os -que en un marco de emergencia sanitaria mundial- asumen este desafío con responsabilidad y gran idoneidad”, aseguró al finalizar.
Este proyecto comenzó en el 2020 a partir de un proyecto que recibió el financiamiento conjunto del Ministerio de Ciencia, Tecnología e Innovación a través de la Agencia Nacional de Promoción de la Investigación, el Desarrollo Tecnológico y la Innovación (Agencia I+D+i), y la Fundación Bunge y Born, en el marco de la “Unidad Coronavirus COVID-19” y actualmente recibe el apoyo de esta Unidad del MINCYT.
Los resultados preliminares presentados son parte de un trabajo colaborativo entre el Ministerio de Salud de la Provincia de Buenos Aires, quien coordina y diseña el protocolo general, realiza las convocatorias, extracciones y envíos de las muestras, el MINCYT, quien financia y el Laboratorio de Inmunopatología del IBYME que realiza los estudios específicos de respuesta inmune celular en personas vacunadas y recuperadas de COVID-19 mediante una plataforma y metodología desarrollada por ellos mismos. Esta plataforma es única en América Latina y una de las pocas del mundo que permiten estudiar la inmunidad de manera integral y a largo plazo.
(Prensa GBA)
Si querés seguir informado podés seguirnos en las cuentas en nuestras redes sociales en Facebook y Twitter o suscribirte en Google News.